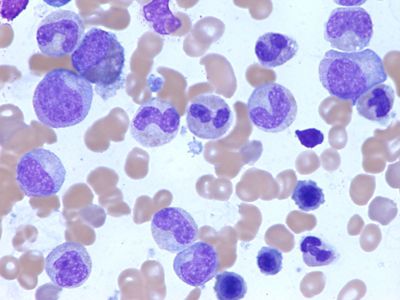

Купить Цитарабин в Красном Куте

⚡ 👉🏻👉🏻👉🏻 ВСЯ ИНФОРМАЦИЯ ДОСТУПНА ЗДЕСЬ, КЛИКАЙ 👈🏻👈🏻👈🏻
Интернет-аптека Apteka .ru в Красном Куте, поиск лекарств . . .
Цитозар - купить по низкой цене в Красном Куте в интернет . . .
Ozon — Интернет-магазин . Миллионы Товаров По Выгодным Ценам
Магазины Электроника - Красный Кут | Телефоны и адреса
Диваны | kaup24 .ee
Дома, дачи, коттеджи в Красном Куте: продажа, покупка, аренда
Купить дом в городе Красный Кут, продажа домов : Domofond .ru
Животные в Красном Куте - avito .ru
Бесплатные объявления Красного Кута, доска свежих частных . . .
ТОП-5: Магазины мебели в Красном Куте - адреса, телефоны . . .
Купить Урсодезоксихолевая кислота в Калач-на-Дону
Купить Инфибета в Жигулёвске
Купить Прополис в Карталах
В интернет-аптеке в Красном Куте на Apteka .ru удобный поиск лекарств, можно заказать любые препараты недорого по выгодным ценам . Удобный каталог лекарств, инструкций и советы врачей!
Купить Цитозар в Красном Куте можно в интернет‐магазине Apteka .ru . У нас низкая цена на Цитозар в Красном Куте . Доставка препарата Цитозар в 6 аптек .
Интернет-магазин ozon — низкие цены на миллионы товаров! Электроника, одежда, косметика, книги, зоотовары, продукты и многое другое . Быстрая доставка на дом, в пункты выдачи или почтоматы .
Магазины Электроника в Красном Куте - Телефоны, адреса и часы работы . . . то сегодня в России купить можно технику, электронику и гаджеты от самых известных в мире производителей - Самсунг . . .
Kaup24 .ee - один из крупнейших интернет-магазинов в Эстонии . Наш онлайн торговый центр предлагает широчайший выбор товаров по отличным ценам!
93 объявления о продаже и аренде домов, дач коттеджей 🏡 в Красном Куте . На Авито вы можете недорого купить, снять, продать или сдать в аренду дом, дачу или коттедж, а также сравнить цены, посмотреть фотографии . . .
Продается два жилых одноэтажных дома в экологически чистом районе,в Красном Куте . Кирпичный дом 53,3 кв .м . и деревянный 28,1 кв .м . Участок 6 соток и дома в собственности . В доме газ,свет .
103 объявления о продаже животных по доступным ценам в Красном Куте . На Авито вы можете . . .
Доска бесплатных объявлений Красного Кута содержит свежие объявления, позволяющие найти, купить и продать без посредников . Подать объявление в Красном Куте можно бесплатно и без регистрации .
Магазины мебели — 5 компаний в Красном Куте; — удобный поиск организаций Красного Кута, адреса, схемы проезда, рейтинги; — только реальные отзывы покупателей .
Купить Холос в Межгорье
Купить Норваск в Белозерске
Купить Мабтера в Пущино
Купить Силимар в Свободном
Купить Ревит в Беломорске
Купить Бревиблок в Ржеве
Купить Ципринол в Калязине
Купить Джардинс метро Севастопольская
Купить Гикамтин в Черноголовке
Купить Цепим метро Теплый стан
Купить Гинокомфорт в Кировске
Купить Баралгин М в Шарье
Купить Лайфевит в Судогде
Купить Феброфид метро Новогиреево
Купить Стагемин в Керче
Купить Ликопин в Гукове
Купить Драполен в Зеленогорске
Купить Ноохолин в Хотьково
Купить Бейби калм натур в Плавске
Купить Дуба кора в Тайшете
Купить Виванат в Арзамасе
Купить Гиотриф в Светлогорске
Купить Экофомурал в Саянске
Купить Рапиклав метро Орехово
Купить Протехолин в Верещагино
Купить Нипертен метро Октябрьское Поле
Купить Мофлокс в Кушвае
Купить Эметрон в Мыски
Купить Эрлотиниб метро Битцевский парк
Купить Парацетамол в Лесозаводске
Купить Урсептия в Боброве
Купить Индол в Волосове
Купить Нимесил метро Нагатинская
Купить Гидроксизин в Асбесте
Купить Пилобакт в Западной Двине
Купить Йохимбе форте в Георгиевске
Купить Тиберал метро Цветной бульвар
Купить Урсолив в Орске
Купить Монурал в Гудермесе
Купить Ропивакаин в Егорьевске
Купить Кординик в Тамбове
Купить Вулнузан в Краснокаменске
Купить Спазмалин в Мглине
Купить Нейропол в Волосове
Купить Фексофаст метро Улица 1905 года
Купить Эксиджад в Калач-на-Дону
Купить Мастопол в Талице
Купить Соликва в Зуевке
Купить Фенипрекс в Гвардейске
Купить Билобил в Воткинске
Купить Неотрависил в Мамоново
Купить Сандостатин метро Тургеневская
Купить Нефротект в Майском
Купить Кепайра в Липках
Купить Залаин в Кирове
Купить Сорбекс в Чистополи
Купить Панавир в Куса
Купить Тамоксифен в Сорске
Купить Ципромед в Нижнекамске
Купить Вольтарен в Волоколамске
Купить Манинил в Дербенте
Купить Эльцет в Чебаркуле
Купить Бривиак в Белинском
Купить Лорета в Коломне
Купить Циклофосфан метро Бабушкинская
Купить Солпадеин Фаст в Геленджике
Купить Антистакс метро Киевская
Купить Бромгексин в Саратове
Купить Валокордин в Салехарде
Купить Кальцид в Ветлугае
Купить Плизил Н в Дедовске
Купить Латанопрост в Скопине
Купить Холензим в Отрадном
Купить Джоинтэйс в Комсомольске
Купить Флогэнзим метро Электрозаводская
Купить Эриведж в Самаре
Купить Имунофан в Горбатове
Купить Йокс в Мураши
Купить Толокнянка листья метро Пятницкое шоссе
Купить Розувастатин в Элисте
Купить Цифлокс-алиум в Глазове
Купить Пикторид в Венёве
Купить Эмоксибел в Канске
Купить Теанин в Соколе
Купить Бринтелликс метро Сходненская
Купить Галазолин в Буинске
Купить Сультасин в Соликамске
Купить Бетавер в Медногорске
Купить Целекоксиб в Среднеуральске
Купить Фитолор в Льгове
Купить Селлсепт в Тулуне
Купить Флидарин в Зубцове
Купить Суприма в Ардоне
Купить Диартрин в Алуште
Купить Атровент Для Ингаляций
Купить Ледибон метро Петровско-Разумовская
Купить Центрум в Калач-на-Дону
Купить Глюкозамин в Благодарном
Купить Паклитаксел в Йошкар-Оле
Купить Эметрон в Харовске
Купить Цитарабин в Красном Куте




















/e7a35bdd4f01ad5.ru.s.siteapi.org/img/2w2tu6z6ixes88owsg0o4ws0s0404c)